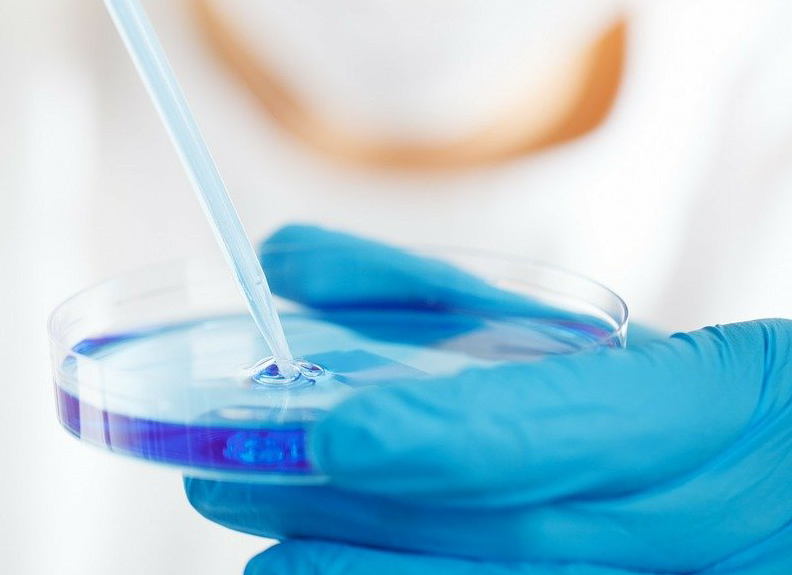

The "ECO X PLORER" plan is a recruitment and training project for high potential talents with an undergraduate degree and above, which are finally selected by the general manager of the company through direct interview. It is hoped that after coming to the company, it will rapidly grow into the backbone of the company and become the pioneer of ecological economy.
The word "ECO" has the meaning of ecological economy, which is consistent with the meaning of the company's brand slogan of "Green driving, Driving green". The first three letters of Economy are "ECO", which can refer to "Ecombine"in this English name.
Explanation of the word "EXPLORE": "EXPLORE" has the meaning of exploration and research, and the verb "PLOR" followed by "ER" can be translated here as the person of exploration.Interpretation of "ECO X PLORER": To sum up, this word is a combination and can be translated as the pioneer of ecological economy.
-

Join丨Selection period
September to June of the next year
丨Implementation of talent program
丨Interview management (preliminary ones, general manager final ones)
丨Screening and contracting management
丨Group management
-

Cultivation丨Observation culture period
12 months
丨Induction course
丨Two-tutor management
丨Work in shifts at the production line
丨Differential rotation
丨Assessment and incentive mechanism
-

After becoming a regular丨Value output period
12 months
丨Regular communication
丨Team building activities
丨Employment confirmation and reporting
丨Post probation evaluation
丨Skills and professional quality
丨Project experience (including non-engineering projects)
-

Development | becoming a true pioneer
12 months
丨Professional sequence
丨Managerial sequence
丨Strategic reserve team (extra R&D and management project experience)
丨Strategic development post reserve
丨Talent reserve for key projects
丨Management talent reserve
丨Reserve of basic management posts
丨Technical personnel reserve for key projects
丨Meet the needs of the post and undertake the special work of the post

Management Trainee | Employee
Technician
Assistant Engineer
Engineer
Senior
Engineer
Management Trainee | Employee
Supervisor
Deputy Manager
Manager
Chief
Inspector





